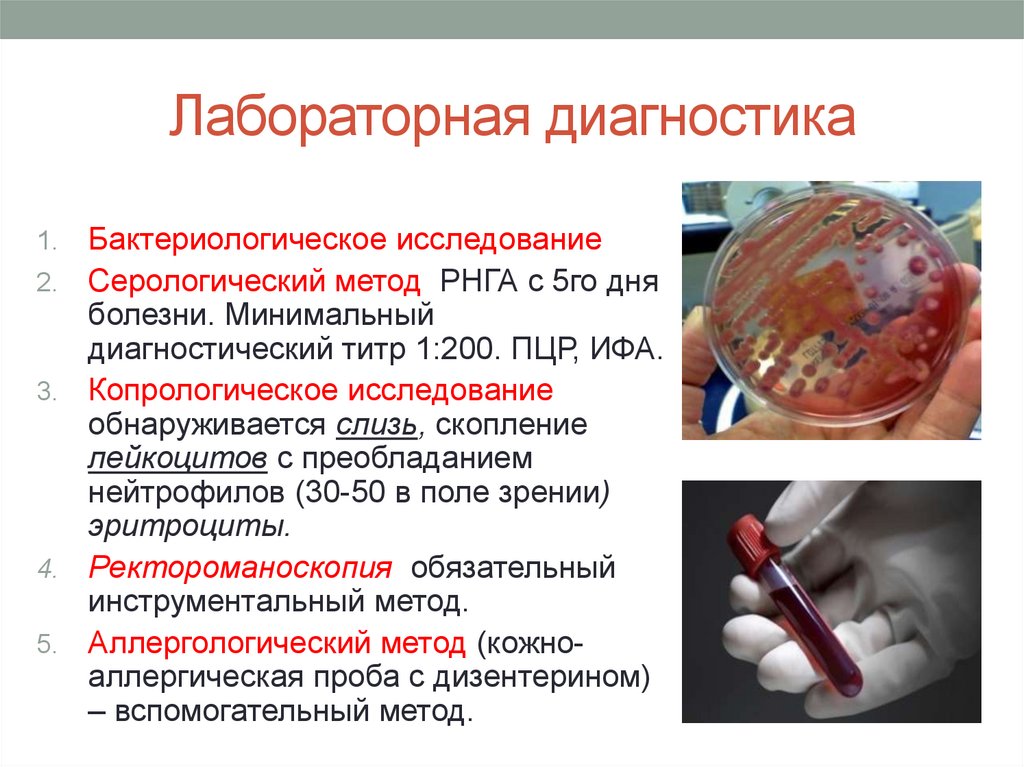

Similar presentations:
Дизентерия (шигеллез)
1.
Государственное автономноепрофессиональное образовательное
учреждение «Казанский медицинский колледж»
ЛЕКЦИЯ № 3
Дизентерия (шигеллез)
Преподаватель инфекционных
заболеваний Мансурова А.Н.
2.
Коды по МКБ-10• A03 Шигеллез
• A03.0 Шигеллез, вызванный Shigella
dysenteriae
• A03.1 Шигеллез, вызванный Shigella flexneri
• A03.2 Шигеллез, вызванный Shigella boydii
• A03.3 Шигеллез, вызванный Shigella sonnei
• A03.8 Другой шигеллез
• A03.9 Шигеллез неуточненный
3.
Дизентерия (шигеллез)• инфекционное заболевание, вызываемое шигеллами,
протекающее с преимущественным поражением
слизистой оболочки дистального отдела толстой
кишки, клинически характеризующееся синдромом
интоксикации, схваткообразными болями в животе,
частым жидким стулом, содержащим примеси слизи и
крови, и сопровождающееся тенезмами.
4.
Этиология• Возбудители дизентерии относят
к семейству Enterobacteriaceae,
объединенных в род Shigella.
• Различают 4 вида шигелл:
1. Шигелла дизентерии
(Григорьева-Шига, ШтуцераШмитца, Лардж-Сакса;
2. Шигелла Флекснера (с
подвидом Ньюкастл);
3. Шигелла Бойда;
4. Шигелла Зонне.
5.
Этиология• Шигеллы —
грамотрицательные,
неподвижные палочки,
спор и капсул не
образуют. Факультативные
анаэробы. Выделяют
эндотоксин и экзотоксин
(цитотоксин,
энтеротоксины,
нейротоксин).
6.
Этиология• Могут длительно сохраняться во внешней среде (до
1,5 месяца). При благоприятных условиях шигеллы
способны к размножению в пищевых продуктах
(салатах, вареном мясе, фарше, вареной рыбе,
молоке и молочных продуктах) С течением времени
нарастает устойчивость шигелл к антибиотикам
разного вида, а к сульфаниламидным препаратам
развилась резистентность практически у всех
штаммов. При температуре 100 °С возбудители
погибают моментально, при 60 °С — в течение 30 мин.
При действии 1%-ного раствора фенола и от прямого
солнечного света возбудители через 30 мин. Наименее
устойчивы бактерии Григорьева–Шиги, наиболее
устойчивы — Зонне и Бойда
7.
Эпидемиология.• Источник инфекции – больной
человек, бактерионосители;
• Механизм передачи – фекальнооральный;
• Путь передачи – алиментарный,
водный, контактно-бытовой;
• Восприимчивость высокая во всех
возрастных группах;
• Сезонность летне-осенняя;
• Иммунитет непродолжительный
типоспецифический иммунитет в
пределах года.
8.
Патогенез.• Шигеллы через рот попадают в желудочно-кишечный
тракт и достигают толстой кишки. С помощью пилей и
белков наружной мембраны возбудители
прикрепляются к клеткам. Благодаря инвазивному
фактору они проникают внутрь клеток, размножаются
там, в результате чего клетки погибают.
• В стенке кишечника образуются изъявление, на месте
которых затем формируются рубцы.
Эндотоксин, освобождающийся при разрушении
бактерий, вызывает общую интоксикацию, усиление
перистальтики кишечника, диарею. В результате
действия экзотоксина наблюдается более выраженное
нарушение водно-солевого обмена, деятельности
ЦНС, поражение почек.
9.
Клиника• Инкубационный период при дизентерии
составляет 1–7 дней (в среднем 2–3).
Классификация дизентерии:
• 1. Острая дизентерия:
- по клиническому варианту течения различают:
• колитический,
• гастроэнтероколитический,
• гастроэнтеритический;
–по степени тяжести различают:
• легкую,
• среднетяжелую,
• Тяжелую,
• Крайне тяжелое течение
– по особенностям течения выделяют:
• стертое,
• субклиническое
• затяжное.
2. Хроническая дизентерия:
• рецидивирующая
• непрерывная.
3. Бактерионосительство шигелл:
• реконвалесцентное
• транзиторное
10.
Клиника• Колитический вариант
• Характеризуется признаками интоксикации и колитического
синдрома
• Легкое течении – болезнь характеризуется умеренно или
слабо выраженной интоксикацией, лихорадка
кратковременна, от нескольких часов до 1–2 сут,
температура тела, повышается до 38 °С. Беспокоят
умеренные боли в левой подвздошной области в основном
перед актом дефекации. У некоторых больных бывают
ложные позывы. Испражнения имеют каловый характер,
кашицеобразную или полужидкую консистенцию, частота
дефекаций до 10 раз в сутки, примесь слизи и крови
макроскопически обнаруживается не всегда и выявляется
только при копроцитологическом исследовании.
Интоксикация и диарея сохраняются в течение 1–3 дней.
11.
Клиника• Колитический вариант
• Среднетяжелое течение. Начало острое.
Температура тела повышается до 38–39 °С и
держится на этом уровне от нескольких часов до
2–4 сут. Повышение температуры
сопровождается ознобом. Больных беспокоят
общая слабость, головная боль, головокружение,
отсутствие аппетита. У пациентов появляются
периодические схваткообразные боли в нижней
части живота, частые ложные позывы на
дефекацию, тенезмы, ощущение
незавершенности акта дефекации. Частота стула
достигает 10–20 раз в сутки. Испражнения
скудные, часто теряют каловый характер и
состоят из одной слизи с прожилками крови.
Интоксикация и диарея продолжаются от 2 до 4–
5 дней.
12.
Клиника• Тяжелое течение характеризуется очень быстрым развитием
заболевания, резко выраженным общим токсикозом, и яркой
симптоматикой колитического синдрома. Болезнь начинается
остро с быстрого повышения температура тела до 40 °С и выше,
сопровождающегося ознобом, пациенты жалуются на сильную
головную боль, резкую общую слабость, полное отсутствие
аппетита. Нередко появляются тошнота, рвота, икота.
Одновременно с интоксикацией развивается выраженный
колитический синдром. Пациентов беспокоят боли в животе,
сопровождающиеся мучительными тенезмами и частыми
позывами на дефекацию и мочеиспускание. Стул более 20 раз в
сутки, нередко число дефекаций трудно сосчитать. Вследствие
пареза сфинктеров у больных возникает зияние заднего прохода,
из которого непрерывно выделяются кровянисто-некротические
массы, часто имеющие вид «мясных помоев». Пульс частый,
артериальное давление, особенно диастолическое, снижено..
Период разгара болезни продолжается 5–10 дней.
13.
Клиника• Крайне тяжелое течение
характеризуется внезапным бурным
началом с быстрым повышением
температуры тела до 41 °С и выше,
сопровождающимся потрясающим
ознобом. Резко выражены явления
крайне тяжелого общего токсикоза.
На этом фоне у больных еще до
появления колитического синдрома
могут развиться осложнения:
инфекционно-токсический шок,
реже — инфекционно-токсическая
энцефалопатия.
14.
Клиника• Гастроэнтероколитический вариант Его основным отличием
является бурное начало после короткого инкубационного периода (6–8
ч и короче), Для него в начальном периоде характерно одновременное
развитие синдромов общей интоксикации и гастроэнтерита. Болезнь
начинается с озноба, повышения температуры тела до 38–39 °С,
появления болей в подложечной области, тошноты и многократной
рвоты. Через некоторое время появляется урчание и боли по всему
животу, императивные позывы на дефекацию. Испражнения
обильные, жидкие, светложелтой или зеленой окраски с кусочками
непереваренной пищи, нередко с примесью слизи. При объективном
исследовании выявляются признаки обезвоживания — заостренные
черты лица, запавшие глаза, сниженная влажность конъюнктив,
сухость слизистых оболочек ротовой полости и глотки. Пульс частый,
слабого наполнения и напряжения, артериальное давление снижено,
тоны сердца ослаблены. На 2–3-й день болезни появляются ложные
позывы, тенезмы, в кале — примесь слизи, иногда крови.
• Легкое течение болезни не сопровождается симптомами
обезвоживания.
• При среднетяжелом течении имеются признаки обезвоживания I
степени. При тяжелом течении болезни развивается обезвоживание II–
III степени с потерей организмом 4–10 % жидкости от массы тела.
15.
Клиника• Стертое течение дизентерии. Это очень легкая
форма с минимальными субъективными
проявлениями болезни. При тщательном клиническом
обследовании определяются спазм и болезненность
сигмовидного отдела толстой кишки.
Ректороманоскопически наблюдается катаральный
проктосигмоидит. При микроскопии испражнений
выявляется много слизи и увеличенное количество
лейкоцитов (более 15 в поле зрения). У значительного
числа таких пациентов заболевание остается не
распознанным.
16.
Клиника• Субклиническая форма острой дизентерии
диагностируется на основании выделения шигелл из
фекалий и выявления нарастания титров
противошигеллезных антител в серологических
реакциях. Клинические проявления заболевания в
этих случаях отсутствуют.
17.
Клиника• Хроническая дизентерия
• Диагноз хронической дизентерии устанавливается в
случае, если заболевание продолжается более 3
месяцев.
• Хроническая дизентерия протекает в виде двух форм:
рецидивирующей и непрерывной.
• Рецидивирующая встречается значительно чаще.
Она характеризуется тем, что при ней обострения
чередуются с периодами полного клинического
благополучия, которые могут продолжаться от
нескольких недель до 2–3 месяцев.
• Непрерывная - периоды ремиссии отсутствуют. \
18.
Клиника• Бактерионосительство шигелл.
• Реконвалесцентное бактерионосительство - у
лиц, перенесших острую дизентерию.
• Подразделяется:
• острое (до 3 месяцев)
• хроническое (более 3 месяцев).
• Транзиторное бактерионосительство — это
однократное выделение шигелл у практически
здорового человека, не болевшего дизентерией и не
имевшего дисфункции кишечника на протяжении
последних 3 месяцев.
19.
Осложнения• Инфекционно-токсический шок (ИТШ) гипертермия,
сменяющаяся гипотермией, бледность и мраморность
кожных покровов, акроцианоз. По мере
прогрессирования шока нарастает выраженная общая
слабость, тахикардия, падение артериального
давления, олигурия.
• Инфекционно-токсическая энцефалопатия (ИТЭ)
возникает обычно на фоне нарастающей
интоксикации. Появляются резко выраженные
головные боли, нарушения сна, психомоторное
возбуждение, возникает нарушение сознания,
менингеальные симптомы.
20.
Лабораторная диагностика1.
2.
3.
4.
5.
Бактериологическое исследование
Серологический метод РНГА с 5го дня
болезни. Минимальный
диагностический титр 1:200. ПЦР, ИФА.
Копрологическое исследование
обнаруживается слизь, скопление
лейкоцитов с преобладанием
нейтрофилов (30-50 в поле зрении)
эритроциты.
Ректороманоскопия обязательный
инструментальный метод.
Аллергологический метод (кожноаллергическая проба с дизентерином)
– вспомогательный метод.
21.
ЛечениеГоспитализация по показаниям;
Показания для госпитализации
Клинические среднетяжелые и тяжелые формы заболевания, дети
до года, пожилые люди, пациенты с тяжелой сопутствующей
патологией
Эпидемиологические работники пищевых предприятий и лица к
ним приравненные, работники детских учреждений, проживающие
в общежитии.
Режим – при тяжелых формах –постельный, при легких и средних
– палатный;
Лечебное питание (стол № 4)
Пища должна быть механически и химически щадящей, легко
усвояемой, полужидкой. Больных кормить небольшими порциями
4-5 раз в день.
22.
ЛечениеЭтиотропная терапия
Препаратами выбора для лечения всех пациентов с
дизентерией являются кишечные фторхинолоны:
офлоксацин по 0,2 г 2 раза в сутки или ципрофлоксацин
по 0,25 г 2 раза в сутки
23.
ЛечениеПатогенетическая терапия
• Больным с легкой и среднетяжелой формой обильное
питье и один из готовых растворов для оральной
регидратации (цитроглюкосалан, регидрон, гастролит и др.)
до 2–4 л/сут. Количество выпитой жидкости должно в 1,5
раза превышать ее потери с испражнениями и мочой.
• При тяжелой интоксикации и обезвоживании показана
инфузионно-дезинтоксикационная
терапия.
Раствор
Рингера и другие полиионные кристаллоидные растворы
(трисоль, лактасол, ацесоль, хлосоль). В большинстве
случаев достаточно введения 1000–1500 мл.
• Энтеросорбенты (для связывания и выведения токсина из
кишечника) — полифепан по 1 столовой ложке 3 раза в
день, активированный уголь по 15–20 г 3 раза в день,
энтеродез по 5 г 3 раза в день, полисорб по 3 г 3 раза в
день, смекта по 1 пакетику 3 раза в день или др.
24.
ЛечениеСимптоматическая терапия
• Спазмолитики (Но-шпа по 0,04 г 3 раза папаверин 0,02 г
3 раза в день) для купирования спазма толстой кишки;
• Ферменты (фестал, панкреатин, креон) для улучшения
пищеварения;
• Бактериологические препараты эубиотики (лактобактерин,
бифидумбактерин, бификол,бактисубтил и др.) для
нормализации состава кишечной микрофлоры;
• Микроклизмы (при выраженных тенезмах) с 0,5%-ным
раствором новокаина в количестве 50–100 мл, введением
ректальных свечей с красавкой или анестезином;
• Комплекс витаминов, состоящий из аскорбиновой кислоты
(500–600 мг/сут), никотиновой кислоты (60 мг/сут), тиамина и
рибофлавина (по 9 мг/сут).
25.
СЕСТРИНСКИЙ УХОД1.
2.
3.
4.
5.
6.
7.
8.
Медсестра контролирует: соблюдение диеты,
контроль передач, соблюдение постельного
режима в острый период, проведение
текущей дезинфекции, а после выпискизаключительной.
Обеспечивает теплым индивидуальным
судном, регистрирует кратность и характер
стула.
Учитывает водный суточный баланс с
фиксацией в истории болезни.
Контроль пульса, АД, ЧДД, Т тела, объема
мочи, веса массы тела, нарушения сознания.
Помощь при рвоте, уход за анальными
складками.
Профилактика пролежней.
Проводит санпросвет работу.
Готовит больного к лабораторному и
инструментальному обследованию.
26.
Выписка из стационара• Производится после полного клинического
выздоровления.
• Отрицательного бактериологического исследования
(однократно), но не ранее чем через 2 дня после
отмены антибиотиков.
• Декректированным пациентам проводят
3х кратное бактериологическое обследование.
27.
Диспансерное наблюдение• Диспансеризации подлежат переболевшие
дизентерией и бактерионосители в течении 12 месяцев.
• Лица, имеющие непосредственное отношение к
производству, хранению, транспортировке и реализаци
и продуктов питания и приравненные к ним
наблюдаются 3 месяца.
28.
Профилактика• Раннее выявление.
Регистрация и лечение всех
больных острыми кишечными инфекц
иями.
• Дезинфекция в очаге (текущая, заклю
чительная).
• Санитарно-просветительная работа.
• Контроль за источниками водоснабже
ния, пищевыми предприятиями.
• Соблюдение мер личной гигиены.
• Повышение неспецифической резист
ентности.
• Специфическая профилактика не раз
работана
29.
Мероприятия в очаге• Наблюдение за очагом в течении 7 дней.
• Осмотр и проведение бактериологического
обследования всех контактных.
• Проведение дезинфекции.

medicine
medicine








